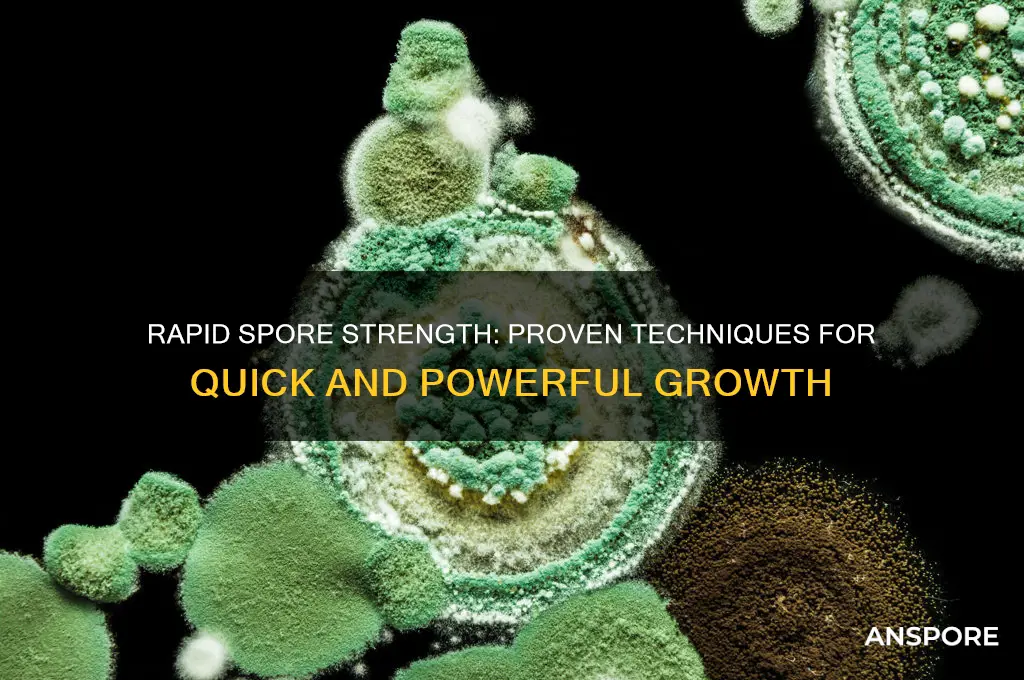
how to get strong fast spore

Getting strong fast in *Spore* requires a strategic approach to evolution and resource management. Players must focus on maximizing their creature’s abilities by prioritizing key attributes such as strength, speed, and health during the Creature Stage. Collecting and consuming as much food as possible early on ensures rapid growth and access to better body parts. Additionally, engaging in combat to defeat stronger creatures grants more DNA points, allowing for quicker upgrades. Utilizing social interactions wisely can also provide advantages, as allies can assist in battles or share resources. By balancing aggression, exploration, and adaptation, players can efficiently evolve their creature into a dominant force in the game’s ecosystem.
| Characteristics | Values |
|---|---|
| Spore Type | Fast Spore (implied, but typically refers to a modded or mutated spore in games like Spore or similar) |
| Strength Gain Method | 1. Genetic Modifications: Modify the spore's DNA to enhance muscle mass, bone density, and overall physical strength. 2. Nutrition: Provide the spore with nutrient-rich food sources high in protein and essential amino acids. 3. Training: Subject the spore to rigorous physical exercises and challenges to stimulate muscle growth and adaptation. 4. Environmental Stressors: Expose the spore to controlled environments with increased gravity or resistance to promote strength development. |
| Growth Rate | Depends on the specific methods used and the spore's natural growth rate. Genetic modifications and optimal conditions can significantly accelerate growth. |
| Strength Metrics | Measured by factors like lifting capacity, endurance, speed, and resistance to damage. |
| Potential Risks | Uncontrolled growth, genetic instability, reduced lifespan, and unforeseen mutations. |
| Ethical Considerations | Modifying living organisms raises ethical questions about animal welfare and potential ecological impact. |
| Game/Context Specifics | The exact methods and limitations will vary greatly depending on the game or context in which "Fast Spore" exists. |
What You'll Learn

Optimize Nutrition for Growth
Spores, whether fungal or bacterial, require precise nutritional conditions to germinate and grow rapidly. The foundation of their strength lies in the availability of essential nutrients, which act as catalysts for metabolic processes. For instance, nitrogen sources like ammonium sulfate or peptone are critical for protein synthesis, while carbon sources such as glucose or sucrose fuel energy production. Without these, spores remain dormant or grow sluggishly. To optimize nutrition for growth, start by selecting a balanced medium that aligns with the spore’s specific requirements. For example, fungal spores often thrive in media containing 2% glucose and 0.5% yeast extract, while bacterial spores may prefer 1% tryptone and 0.5% sodium chloride.
The timing and concentration of nutrient delivery also play a pivotal role. Spores in the early stages of germination are particularly sensitive to nutrient availability. A sudden influx of high-concentration nutrients can shock the spores, while insufficient amounts can stall growth. Gradually increasing nutrient levels, such as starting with a 0.5% glucose solution and escalating to 2% over 24 hours, can mimic natural conditions and promote faster, healthier growth. This method, known as nutrient ramping, is especially effective for heat-activated spores, which often require a gentle transition from dormancy to active metabolism.
Hydration is another overlooked aspect of spore nutrition. Spores must absorb water to initiate metabolic activity, but the quality of water matters. Distilled or deionized water is ideal, as impurities can inhibit growth or introduce contaminants. For example, using tap water with high mineral content can lead to nutrient imbalances, slowing growth. Additionally, maintaining a pH between 6.5 and 7.5 ensures optimal nutrient uptake. A simple adjustment using 0.1M HCl or NaOH can correct pH levels, creating an environment conducive to rapid spore development.
Practical application of these principles requires attention to detail. For home cultivators, pre-sterilizing all equipment and using sealed containers minimizes contamination risk. Commercial growers might employ automated systems to monitor nutrient levels and pH in real time. Regardless of scale, consistency is key. Spores exposed to fluctuating conditions—such as irregular feeding schedules or temperature shifts—may exhibit stunted growth. A controlled environment, paired with a meticulously designed nutrient regimen, ensures spores reach their full potential quickly and efficiently.
Finally, consider the role of micronutrients and supplements. Trace elements like magnesium, iron, and zinc are often required in minute quantities but are essential for enzyme function and DNA synthesis. Adding a micronutrient solution at a concentration of 1 mL per liter of medium can significantly enhance growth rates. Similarly, vitamins such as B12 or biotin, typically added at 10 mg/L, can act as cofactors for critical metabolic reactions. While macronutrients form the backbone of spore nutrition, these micronutrients and supplements are the fine-tuners that optimize growth, ensuring spores develop strength and resilience at an accelerated pace.
Botulism Spores: Can They Cause Illness and Health Risks?
You may want to see also

Ideal Temperature and Humidity Control
Temperature and humidity are the silent architects of spore vitality, dictating whether your spores develop into robust mycelium or wither into dormancy. For optimal germination, maintain a temperature range of 70°F to 75°F (21°C to 24°C). This sweet spot mimics the natural environment where most spore-producing fungi thrive, accelerating metabolic processes without inducing stress. Deviations below 65°F (18°C) can slow growth, while temperatures above 80°F (27°C) may denature enzymes critical for spore activation. Think of this range as the Goldilocks zone—not too cold, not too hot, but just right for rapid, healthy development.
Humidity, the often-overlooked counterpart, is equally critical. Spores require a relative humidity of 70% to 80% to absorb sufficient moisture for germination. Below 60%, they risk desiccation, while above 90%, mold and contamination become imminent threats. Achieve this balance by using a humidifier or placing a tray of water near your spore setup. For precision, invest in a hygrometer to monitor levels, adjusting as needed. Imagine humidity as the lifeblood of your spores—too little, and they starve; too much, and they drown.
Practical implementation involves creating a controlled microclimate. Use a clear plastic container with air holes to retain moisture while allowing gas exchange. Mist the interior walls daily with distilled water to maintain humidity without soaking the spores directly. Pair this with a heating pad set to low, placed beneath the container, to stabilize temperature. This DIY setup costs under $20 and rivals commercial incubators in effectiveness. Think of it as a miniature ecosystem, where every element is fine-tuned for spore success.
Caution: Avoid over-reliance on ambient conditions, especially in fluctuating climates. A sudden drop in nighttime temperature or a dry spell can derail progress. Instead, prioritize consistency. For instance, if your room temperature dips below 68°F (20°C) at night, use a thermostat-controlled heat source. Similarly, in arid environments, a humidifier with a built-in hygrostat ensures stability. These small investments yield outsized returns in spore vigor and germination speed.
In essence, mastering temperature and humidity is less about complexity and more about precision. By maintaining 70°F to 75°F and 70% to 80% humidity, you create an environment where spores not only survive but flourish. Combine this with simple, cost-effective tools, and you’ll witness faster, stronger spore development. It’s not magic—it’s science, applied with care.
Mastering Spore Evolution on Tablet: Tips and Tricks for Success
You may want to see also

Efficient Light Exposure Techniques
Light is the lifeblood of spore development, but not all exposure is created equal. Understanding the nuances of light intensity, duration, and spectrum can significantly accelerate spore maturation and potency. For instance, spores thrive under a specific range of light wavelengths, with blue light (450-470 nm) promoting vegetative growth and red light (620-750 nm) stimulating spore production. This spectral fine-tuning can be achieved using LED grow lights, which allow for precise control over light output. By tailoring the light spectrum to the developmental stage of the spores, cultivators can optimize growth rates and yield.
To implement efficient light exposure, start by positioning your spore culture 6-12 inches beneath the light source, ensuring even coverage without overheating. Gradually increase daily light exposure from 12 hours for young spores to 16-18 hours for mature ones. This mimics natural daylight cycles and prevents stress. For advanced setups, consider using a light meter to maintain a Photosynthetic Photon Flux Density (PPFD) of 100-200 μmol/m²/s, ideal for spore development. Pair this with a timer to automate lighting schedules, reducing human error and ensuring consistency.
A common mistake is overexposing spores to light, which can lead to bleaching or stunted growth. To avoid this, monitor the culture for signs of stress, such as discoloration or slowed growth, and adjust light intensity or duration accordingly. Additionally, rotating the culture periodically ensures uniform light exposure, preventing lopsided development. For those using natural light, supplement with artificial lighting during cloudy days or shorter winter hours to maintain optimal conditions.
Comparing natural and artificial lighting reveals distinct advantages for each. Natural light is cost-effective and provides a full spectrum, but it’s unpredictable and limited by geography and season. Artificial lighting, while requiring an initial investment, offers year-round control and scalability. For hobbyists, a south-facing window with sheer curtains can suffice, while commercial growers may opt for tiered LED racks for maximum efficiency. The key is to balance accessibility with precision, tailoring the setup to your resources and goals.
In conclusion, efficient light exposure is a cornerstone of rapid spore development. By mastering spectral control, maintaining optimal intensity, and adapting to the spores' needs, cultivators can achieve faster, healthier growth. Whether leveraging natural light or investing in advanced setups, the principles remain the same: consistency, observation, and adaptability. With these techniques, even novice growers can unlock the full potential of their spore cultures.
How to Change Your Spore Name: A Step-by-Step Guide
You may want to see also

Proper Substrate Preparation Methods
Substrate preparation is the unsung hero of successful spore germination and mycelial growth. A poorly prepared substrate can hinder colonization, leading to weak or failed yields. The key lies in creating an environment that is both nutrient-rich and sterile, allowing spores to thrive without competition from contaminants. Think of it as laying the foundation for a house—a strong base ensures stability and longevity.
To begin, select a substrate that aligns with the nutritional needs of your spore species. Common choices include rye grain, vermiculite, and manure-based mixes. For instance, rye grain is ideal for initial colonization due to its high starch content, while manure-based substrates are better suited for species that require more complex nutrients. Once selected, the substrate must be pasteurized or sterilized to eliminate competing microorganisms. Pasteurization, achieved by soaking the substrate in hot water (160-180°F for 30 minutes), is less harsh but may not kill all contaminants. Sterilization, using a pressure cooker at 15 PSI for 60-90 minutes, is more reliable but requires careful monitoring to avoid overcooking.
After sterilization, allow the substrate to cool to room temperature in a clean environment. Introducing spores to a hot substrate can kill them instantly. Once cooled, hydrate the substrate to the appropriate moisture level—typically 60-70% field capacity. This ensures the substrate retains enough water to support growth without becoming waterlogged. A simple test: squeeze a handful of substrate; it should feel moist but not release water. Now, inoculate the substrate with spores, ensuring even distribution. Use a sterile tool to mix the spores gently, avoiding contamination.
One often-overlooked aspect is pH adjustment. Most fungi thrive in slightly acidic to neutral conditions (pH 5.5-7.0). Test the substrate’s pH and adjust using agricultural lime or gypsum if necessary. This small step can significantly enhance colonization rates. Finally, maintain proper environmental conditions during incubation—darkness, consistent temperature (70-75°F), and adequate airflow. These factors, combined with a well-prepared substrate, set the stage for robust mycelial growth and, ultimately, strong spore production.
Inoculating Grain with Spores: A Comprehensive Guide to the Process
You may want to see also

Accelerated Sporulation Strategies for Strength
Spores, the resilient survival structures of certain bacteria, fungi, and plants, have long fascinated scientists for their ability to withstand extreme conditions. But what if we could harness their inherent strength-building mechanisms for our own benefit? Accelerated sporulation strategies offer a unique lens into rapid strength development, both in biological systems and metaphorically in human training regimens. By understanding the triggers and processes that drive spores to fortify themselves, we can extract principles applicable to enhancing physical and mental resilience.
Consider the environmental cues that initiate sporulation in bacteria like *Bacillus subtilis*. Nutrient deprivation, temperature shifts, and pH changes act as stressors that prompt the cell to redirect resources toward structural reinforcement. Translating this to human training, incorporating controlled stress—such as progressive overload in weightlifting or intermittent fasting in nutrition—can stimulate adaptive responses. For instance, a study in *Nature Microbiology* highlights how cyclic di-AMP signaling accelerates sporulation by optimizing energy allocation. Similarly, athletes might benefit from periodized training cycles, alternating high-intensity phases with recovery periods, to maximize strength gains without burnout.
One practical strategy inspired by sporulation is the concept of "metabolic priming." Just as spores accumulate protective proteins and peptides during early stages, individuals can preload their systems with strength-enhancing nutrients. Supplementing with 5–10 grams of creatine monohydrate daily, for example, has been shown to increase muscle phosphocreatine stores, enabling more explosive power output. Pairing this with branched-chain amino acids (BCAAs) at a 2:1:1 ratio of leucine, isoleucine, and valine can further support protein synthesis and recovery. Timing is critical—consume these supplements 30–60 minutes pre- and post-workout for optimal absorption.
A cautionary note: accelerated strategies demand precision. Overloading the system without adequate recovery mirrors the inefficiency of sporulation under constant stress. For instance, *B. subtilis* fails to complete sporulation if exposed to prolonged nutrient deprivation, leading to cellular exhaustion. Similarly, athletes risk injury or plateauing if they neglect rest days or ignore signs of overtraining. Monitoring biomarkers like cortisol levels or tracking subjective recovery scales can help calibrate intensity. For older adults (ages 50+), reducing training volume by 20–30% while maintaining frequency can preserve gains without compromising joint health.
Finally, the psychological parallels between sporulation and strength training are worth exploring. Spores endure dormancy, a state of suspended animation, to emerge stronger when conditions improve. This mirrors the mental resilience required in long-term strength programs. Adopting a growth mindset, where setbacks are viewed as temporary and surmountable, can enhance adherence. Techniques like visualization or journaling progress can reinforce this mindset. Just as spores leverage adversity to thrive, individuals can transform challenges into catalysts for unparalleled strength.
Can Coccidioides Spores Travel Through Air and Spread Infections?
You may want to see also
Frequently asked questions
Focus on evolving aggressive traits early, such as claws, spikes, and powerful attacks, while prioritizing health and speed upgrades to dominate predators and prey.
Hunt frequently, socialize with other creatures, and complete epic hunts to gain DNA points rapidly, allowing you to evolve stronger traits faster.
Prioritize offensive traits like venom, electric attacks, and pack hunting abilities, along with defensive traits like armor and high health, to ensure survival and dominance.
No, you must progress through each stage (Cell, Creature, Tribal, Civilization, Space) to unlock advanced abilities and resources, but you can speed up early stages by focusing on key objectives.
Pack hunting allows you to take down larger prey and fend off stronger predators, earning more DNA points and resources to evolve powerful traits quickly.







